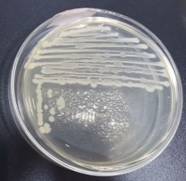
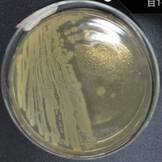

为培养员工微生物学实验技能,激发员工探索微生物世界的兴趣,提高员工创新思考和能力,12月6日,“普析杯”第六届老员工微生物学实验技能竞赛在北校区知达楼生物实验中心落下帷幕。本次比赛由教务处主办、williamhill微生物学团队承办。
竞赛分初赛和决赛两个阶段。11月15日至11月22日,在微生物学省在线开放课程平台上开展初赛。12月6日下午,在生物实验中心实验室进行了决赛。经初赛选拔,共有40名员工进入决赛。决赛项目分为无菌操作技术和微生物染色技术两个项目,最终评出特等奖1人、一等奖2人、二等奖4人、三等奖6人和优胜奖27人。
微生物学实验技能竞赛是课堂教学的有效延伸,是对参赛选手在微生物学省在线开放课程线上、线下学习效果和专业综合素质的一次大检验,为全校爱好微生物学的员工提供了一个展示自我、挑战自我的舞台。本次竞赛得到了北京普析通用仪器有限责任公司的冠名赞助。
特等奖 |

|

|
Z食品181-盛翔-项目4-G+菌 |
Z食品181-盛翔-项目4-G-菌 |
一等奖 |

|

|
B食品181-范莹-项目4-G+菌 |
B食品181-范莹-项目4-G-菌 |
一等奖 |

|

|
B生物181-姜桂来-项目1-S.aureus |
B生物181-姜桂来-项目1-E.coli |
二等奖 |

|
|
B海洋183-石海莹-项目1-S.aureus |
B海洋183-石海莹-项目1-E.coli |
二等奖 |

|

|
B生物181-陈欢-项目1-S.aureus |
B生物181-陈欢-项目1-E.coli |
二等奖 |

|

|
B生物181-李旭东-项目4-G+菌 |
B生物181-李旭东-项目4-G-菌 |
二等奖 |

|

|
B海洋182-任照薇-项目4-G+菌 |
B海洋182-任照薇-项目4-G-菌 |
三等奖 |

|

|
Z食品181-霍璐璐-项目1-S.aureus |
Z食品181-霍璐璐-项目1-E.coli |
三等奖 |
|

|
B环境181-于广成-项目1-S.aureus |
B环境181-于广成-项目1-E.coli |
三等奖 |

|

|
B海洋183-孙中伟-项目1-S.aureus |
B海洋183-孙中伟-项目1-E.coli |
三等奖 |

|

|
Z食品181-丁钰芯-项目4-G+菌 |
Z食品181-丁钰芯-项目4-G-菌 |
三等奖 |

|

|
B生物192-高典-项目4-G+菌 |
B生物192-高典-项目4-G-菌 |
三等奖 |

|

|
B生物182-孙国凤-项目4-G+菌 |
B生物182-孙国凤-项目4-G-菌 |
图1 williamhill威廉希尔“普析杯”第六届老员工微生物学实验技能竞赛”代表性获奖作品展

图2 参赛选手与评委合影



图3决赛现场